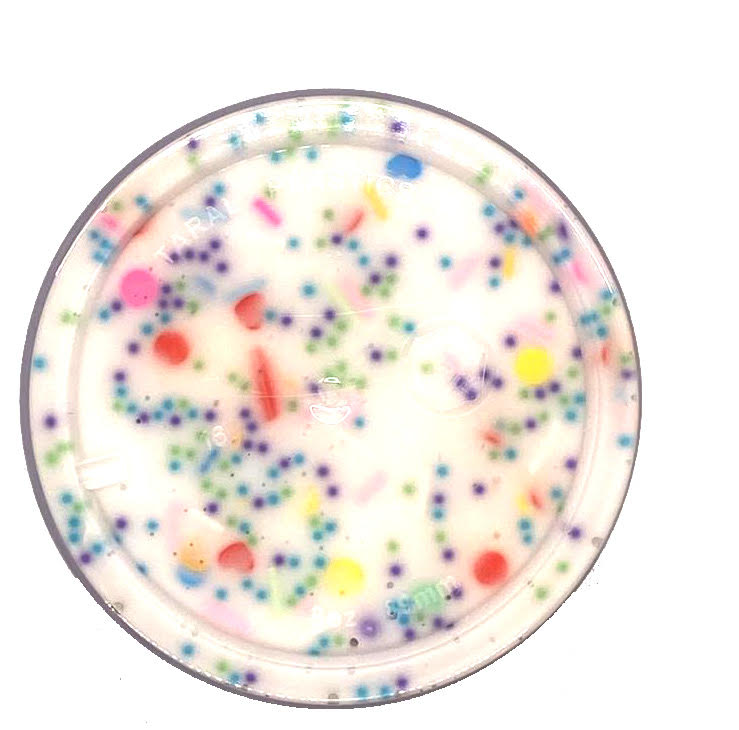

FunFetti Frosting
$13.99
Your shopping bag is empty
Go to the shop